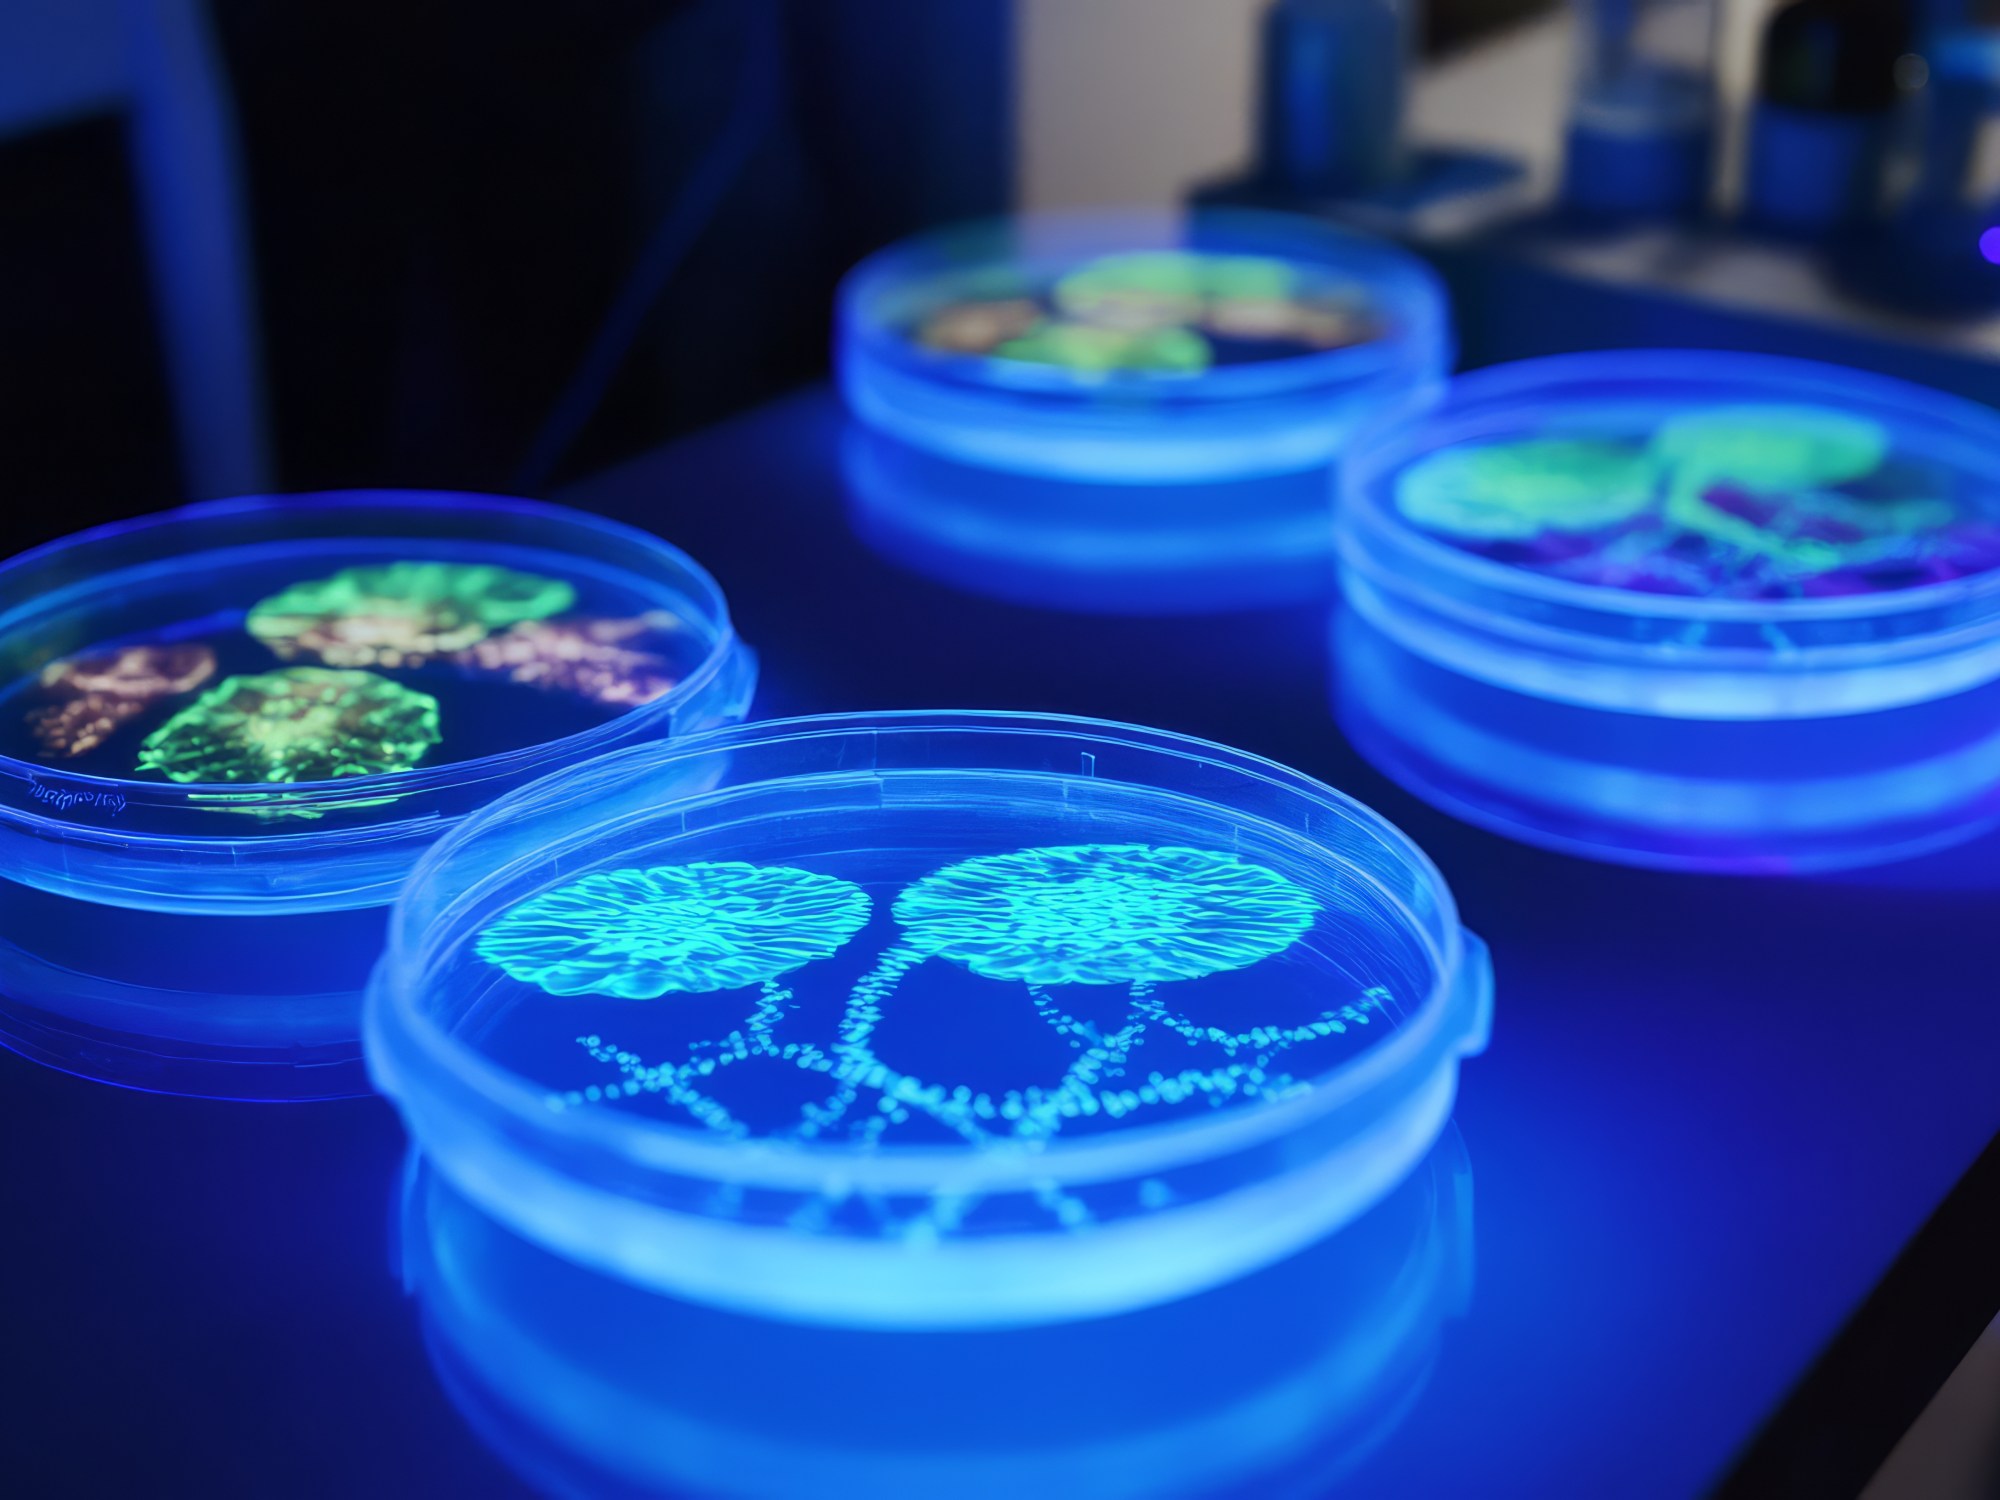

Blog Post by : Karun Tyagi
In an era where sustainability is no longer a choice but a necessity, the textile industry is grappling with a myriad of challenges that require radical innovation. From the depletion of natural resources to environmental pollution caused by traditional processes, the stakes are high. Amid these challenges, biohacking—a term that traditionally evokes images of self-experimentation and biological enhancement in humans—has emerged as an intriguing, innovative approach that holds tremendous potential for revolutionizing industries, including textiles.
So, what exactly is biohacking, and how can it be leveraged to create a more sustainable textile value chain? Let’s dive into the science, the possibilities, and how companies can adopt biohacking principles to lead the way in eco-friendly textile production.
Understanding Biohacking: More Than Just a Trend
Biohacking, at its core, refers to the process of making modifications to biological systems—be it human biology, plant genetics, or microbial organisms—to optimize their performance or generate entirely new capabilities. While biohacking is often associated with personal health optimization, its principles extend well beyond individuals to systems and industries.
In the context of manufacturing, biohacking involves using biotechnology to manipulate living organisms or biological materials to produce sustainable solutions. This can range from developing bio-based materials, enhancing microbial fermentation for fabric production, or creating new biopolymers that mimic traditional textiles without the environmental burden.
The goal is not only to reduce the environmental impact but also to unlock new functionalities in textiles, such as biodegradable fabrics, enhanced durability, or even textiles that self-heal or respond to environmental stimuli.
While biohacking offers exciting potential for revolutionizing the textile industry through sustainable practices, it’s not without environmental challenges. Balancing the benefits and risks requires careful consideration of the trade-offs, regulatory frameworks, and long-term ecological impacts. Below are some key challenges associated with biohacking in the textile industry and how companies can establish a balanced approach.
1. Genetic Modification and Ecological Disruption
One of the central concerns with biohacking is the use of genetically modified organisms (GMOs) in textile production. Whether it involves genetically engineered cotton, microbial fermentation for dyes, or mycelium leather, the use of bioengineered organisms raises potential risks to natural ecosystems.
Potential Risks:
- Unintended Spread of GMOs: There is a risk that bioengineered organisms could spread outside controlled environments and disrupt natural ecosystems. For example, if genetically modified plants or microorganisms crossbreed or interact with wild species, they could cause unforeseen changes to biodiversity and ecosystem balance.
- Resistance Development: Over time, pests or bacteria could develop resistance to genetically engineered traits, such as pest-resistant cotton, leading to a need for stronger interventions and reducing the sustainability of the solution.
Balancing the Risks:
- Strict Containment Protocols: Companies using GMOs for textiles must establish stringent containment and monitoring protocols to prevent the release of bioengineered organisms into natural environments. This includes creating physical barriers, using sterile strains that cannot reproduce in the wild, and regular testing for unintended consequences.
- Regulatory Oversight: Governments and regulatory bodies need to develop robust frameworks to monitor and control the use of GMOs in industries like textiles. Strict approval processes and safety assessments should be required before any biohacked organism is used at scale.
2. Energy and Resource Intensiveness of Biofabrication
While biohacking promises more sustainable alternatives to traditional textile production, some biofabrication processes can be energy-intensive, especially in their early stages of development.
Potential Risks:
- High Energy Demand: Lab-grown materials, such as biofabricated leather or lab-grown cotton, often require highly controlled environments, including temperature, humidity, and sterilization, which can result in high energy consumption.
- Resource Input for Growth: Some biohacked solutions may still require substantial inputs of water, nutrients, or other raw materials to maintain the growth of bioengineered organisms, negating some of the environmental benefits.
Balancing the Trade-offs:
- Investment in Renewable Energy: Companies adopting biofabrication methods should simultaneously invest in renewable energy sources such as solar or wind power to offset the energy demands of biohacked textile production. This can significantly reduce the carbon footprint of biofabricated materials.
- Optimizing Growth Conditions: Continuous R&D is needed to improve the efficiency of biohacked processes. For example, optimizing nutrient use and energy requirements for microbial fermentation or biofabrication can help reduce resource inputs and make the overall process more sustainable.
3. Waste Generation and End-of-Life Management
Although biohacking offers the potential for biodegradable and eco-friendly textiles, the industrial processes associated with biohacked materials still generate waste. In some cases, this waste can contain by-products that need to be carefully managed to avoid environmental harm.
Potential Risks:
- Non-Biodegradable By-products: Some biohacking processes may generate by-products that are not biodegradable or difficult to recycle. For instance, microbial fermentation used in dye production can result in leftover biomass or residual solvents that require proper disposal.
- Toxicity of New Materials: New biopolymers or bioengineered fabrics may behave differently in natural environments than expected. For example, bio-based synthetic fibers might not degrade as quickly as predicted or could release harmful substances as they break down.
Balancing the Trade-offs:
- Circular Economy Models: To mitigate waste issues, companies should adopt circular economy principles, ensuring that biohacked textiles are designed with end-of-life management in mind. This could include creating closed-loop systems where by-products and waste are recycled or repurposed within the production process.
- Lifecycle Assessments (LCA): Regular lifecycle assessments should be conducted for biohacked products to assess their environmental impact from raw material sourcing to end-of-life disposal. This data can be used to refine processes and reduce negative environmental outcomes.
4. Ethical and Socioeconomic Implications
The use of biohacking and biotechnology in textiles could lead to unintended ethical and socioeconomic consequences. This includes concerns about the ownership of genetic resources, the displacement of traditional farming practices, and the broader implications for labor markets in the textile industry.
Potential Risks:
- Biopiracy and Intellectual Property: Biohacking often involves manipulating natural genetic resources, which raises concerns about biopiracy, where companies may profit from genetic materials sourced from developing countries without proper compensation or benefit-sharing.
- Impact on Traditional Farmers: The adoption of biohacked fibers and fabrics could marginalize traditional farming communities, especially those dependent on cotton or wool production, as demand for bioengineered alternatives increases.
- Job Displacement: As biohacked textiles become more prevalent, there could be a shift away from traditional manufacturing roles toward highly technical, lab-based jobs, which may leave low-skilled workers in the textile industry vulnerable.
Balancing the Trade-offs:
- Fair Benefit Sharing: Ethical frameworks should be established to ensure that biohacked materials, especially those derived from natural genetic resources, are developed in collaboration with local communities and that profits are equitably shared. Intellectual property laws should be designed to protect traditional knowledge and resources from exploitation.
- Support for Traditional Industries: Companies implementing biohacked textile solutions can strike a balance by supporting traditional farmers and industries through investments in sustainable agricultural practices. Blending traditional materials with biohacked innovations could also create hybrid solutions that support both industries.
- Training and Upskilling: Companies and governments must invest in education and training programs to upskill workers in the textile industry, preparing them for the new opportunities presented by biohacked textiles, while also ensuring that jobs are created in rural areas where traditional textiles were once produced.
5. Public Perception and Consumer Acceptance
One of the more intangible challenges of biohacking is public perception. Consumers may be wary of wearing clothes made from genetically engineered organisms, microorganisms, or lab-grown materials. This skepticism can hinder the widespread adoption of biohacked textiles, even if they offer substantial environmental benefits.
Potential Risks:
- GMO Concerns: Despite scientific advancements, public mistrust of GMOs remains prevalent, particularly when it comes to food and textiles. The idea of wearing materials produced by bacteria or fungi might be unappealing to some consumers.
- Lack of Transparency: If consumers feel that companies are not transparent about how biohacked textiles are made or the potential risks involved, there could be a backlash against bioengineered products.
Balancing the Trade-offs:
- Consumer Education: Transparent communication is key to overcoming public skepticism. Companies should invest in educational campaigns that explain the benefits of biohacked textiles, their safety, and their positive impact on the environment. This can help build consumer trust and acceptance.
- Certification and Labeling: Certification schemes and eco-labeling can play an important role in reassuring consumers that biohacked textiles are safe, ethical, and sustainable.
Conclusion: A Balanced Path Forward
The future of sustainable textile production through biohacking is full of potential, but it also comes with significant challenges that need to be addressed to minimize environmental risks. By balancing innovation with ecological responsibility, ethical practices, and consumer trust, companies can harness biohacking to drive positive change in the textile industry.
To strike this balance, a multi-faceted approach is necessary:
- Rigorous testing and regulatory frameworks to ensure environmental safety and public confidence.
- Continuous innovation to reduce the energy and resource demands of biohacked processes.
- Ethical collaborations with local communities and traditional industries to ensure inclusivity and fair benefit-sharing.
- Transparent consumer engagement to build trust and foster widespread acceptance.
As the textile industry embraces biohacking, it’s important to remain mindful of the trade-offs and establish sustainable practices that will enable a new, eco-friendly era for fashion and textiles, without compromising the environment or social equity in the process.